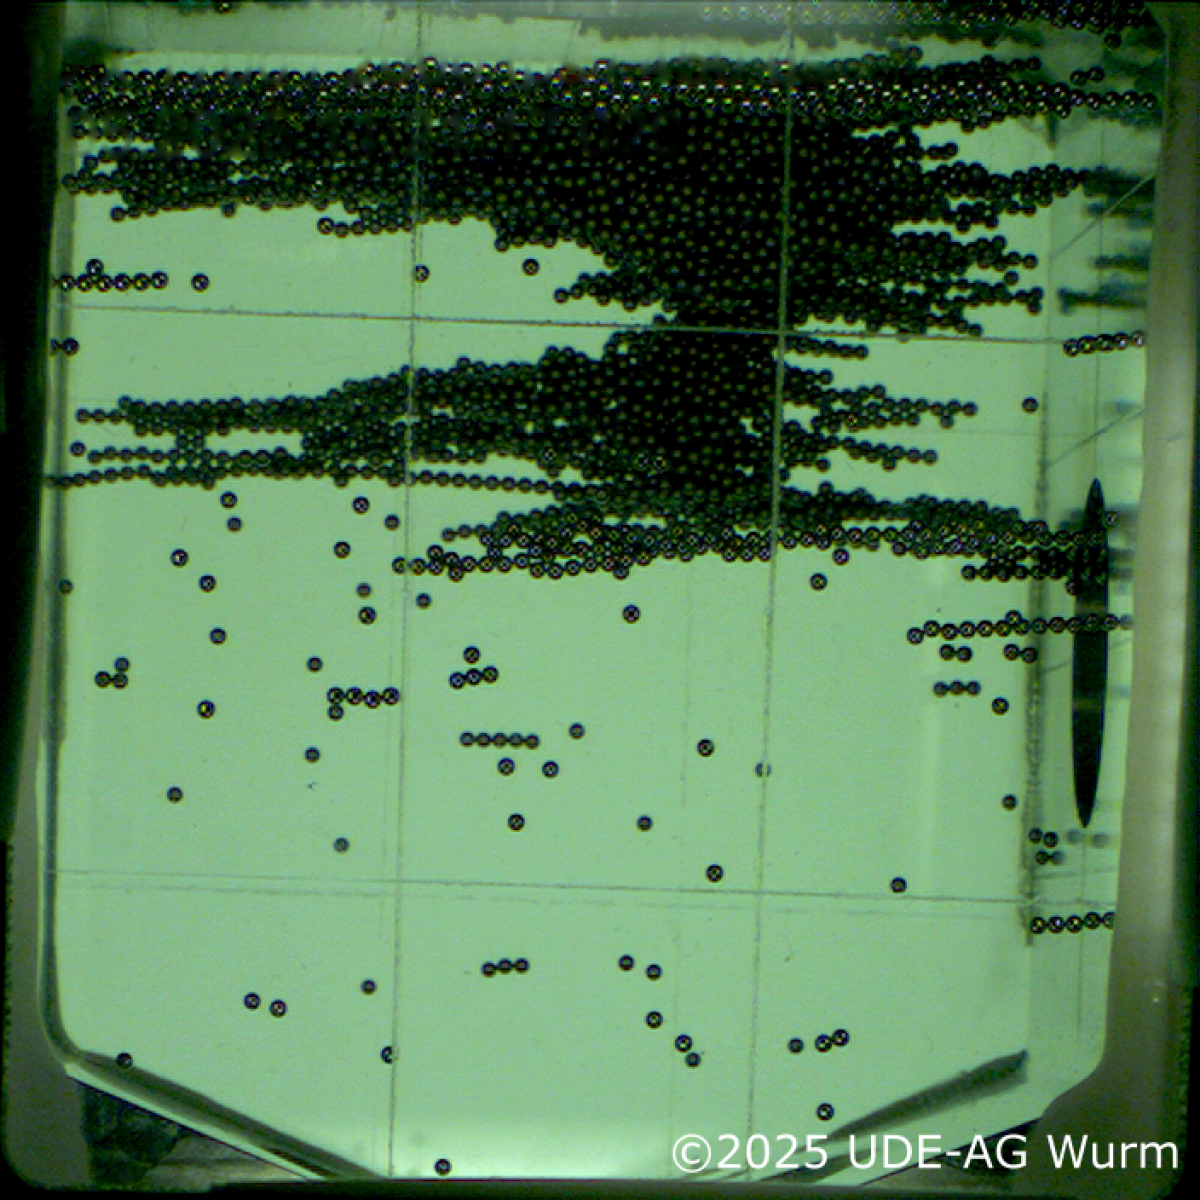

Newsarchiv 2025
22.12.2025Neues Orientierungssemester Physik - Fit für dein Studium!
Physiker:innen sind auf dem Arbeitsmarkt gefragt: Ob bei der Entwicklung Künstlicher Intelligenz, Quantencomputing, in der Energieforschung oder im Lehramt. Um Studieninteressierten nun den Einstieg zu erleichtern oder die Grundlagen von Physikstudierenden aufzufrischen, hat die Fakultät für Physik der Universität Duisburg-Essen ein neues Orientierungssemester entwickelt. Anmeldungen zum kostenlosen 12-wöchigen Programm sind ab sofort und bis zum 1. April möglich. Los geht es dann am 27. April 2026.
Die Teilnehmenden wiederholen und vertiefen schulnahe Inhalte aus der Mathematik und Physik und bauen damit ein sicheres Fundament auf. „Unser Ziel ist ein entspannter und gut vorbereiteter Start ins Studium. Klare Strukturen, ein sicherer fachlicher Einstieg und Freude am Fach sind dafür entscheidend“, erklärt der Studiendekan Prof. Dr. Hermann Nienhaus. Außerdem gibt es viele Gelegenheiten, zukünftige Mitstudierende kennenzulernen und sich schon vor Studienbeginn auf dem Campus zurechtzufinden. Der Unterricht findet in den sogenannten Keksdosen auf dem Campus Duisburg statt und ist damit ganz nah dran an den spannenden Laboren und Forschungsthemen.
Das Orientierungssemester Physik richtet sich an angehende Studierende der Physik, Energy Science sowie des Lehramts Physik. Auch Studierende anderer Fächer der UDE sowie Physikstudierende, die ihre Grundlagen auffrischen möchten, sind willkommen. Besonders attraktiv ist das Angebot für junge Menschen, die nach einem Gap Year den Übergang ins Studium erleichtern wollen.
Das Programm kommt ohne verpflichtende Prüfungen aus. Dennoch ist es teilweise möglich, Prüfungen abzulegen, die nach der Einschreibung in einen regulären Studiengang an der Fakultät für Physik anerkannt werden. Die Teilnehmenden erhalten einen eingeschränkten Studierendenstatus und profitieren von Bibliothekszugang und vergünstigtem Mensaessen.
Das Orientierungssemester im Überblick:
Start: 27. April 2026 | Ende: 23. Juli 2026
Programmtage: Dienstag · Mittwoch · Donnerstag (Pfingstferien/frei: 25. - 29. Mai)
Anmeldeschluss: 1. April 2026
Die Plätze sind begrenzt. Nach dem 1. April ist eine Anmeldung nur noch nach Verfügbarkeit möglich.
Weitere Informationen:
https://udue.de/osem
Dr. Anne-Kristin Pusch, anne-kristin.pusch@uni-due.de
Redaktion: Jennifer Meina, Tel. 0203/379-1205, jennifer.meina@uni-due.de
17.12.2025Völlig schwerelos! Projekt des MAVERICK-Teams für das REXUS-Raketenprogramm angenommen!
Partystimmung beim Projektteam MAVERICK „Wir sind unglaublich stolz und freuen uns, dass unser MAVERICK-Projekt für den 17. Zyklus des REXUS/BEXUS-Programms ausgewählt wurde!“ Am 24. und 25. November 2025 hatte das Team aus der Forschungsgruppe von Prof. Dr Gerhard Wurm, bestehend aus Christopher Grünebeck, Kai Stuers, Nico Wenders und Gretha Swantje Völke, erfolgreich an einem Auswahl-Workshop beim Deutschen Zentrum für Luft- und Raumfahrt (DLR) in Bonn teilgenommen. Ihr Experiment zum Thema Planetenentstehung geht voraussichtlich im Frühling 2027 an Bord einer fast sechs Meter langen Rakete auf die Reise bis über die Stratosphäre in eine Höhe von bis zu 80 Kilometern. Das Team fährt für zwei Wochen nach Kiruna, Schweden, um den Start zu betreuen.
Aus winzigen Staubkörnern bilden sich nach und nach größere Klumpen, bis schließlich ganze Himmelskörper entstehen. Welche Rolle spielen in der frühen Phasen der Planetenentstehung die magnetischen Felder, die in den Regionen, in denen junge Planeten entstehen, allgegenwärtig sind? Beim Experiment werden eisenhaltige oder normale Eisenkugeln unter Schwerelosigkeit einem Magnetfeld von wenigen mT ausgesetzt werden. Die Schwerelosigkeit wird für zwei Minuten anhalten.
„Wir freuen uns auf alles, was das Projekt in Zukunft für uns bereithält – von neuen Erkenntnissen bis hin zum Start in Nordschweden im Jahr 2027. Die Reise hat gerade erst begonnen!“
11.12.2025NRW-Rückkehrer Dr. Juba Bouaziz – Quantenmaterialien für Future Computing
Klassische Computer geraten bei der Mustererkennung und der Berechnung optimaler Lösungen für große Systeme an ihre Grenzen. Vielversprechend sind neue Technologien wie neuromorphes Computing und Quantencomputing. Sie setzen jedoch Materialien mit neuen magnetischen und elektronischen Eigenschaften voraus. Hierzu forscht der Theoretische Physiker Dr. Juba Bouaziz. An der Universität Duisburg-Essen hat er das exzellente Umfeld gefunden, das er dafür benötigt. Der 35-Jährige kehrt dank des NRW-Rückkehrprogramms aus Japan nach Deutschland zurück und wird eine eigene Nachwuchsgruppe aufbauen.
Dr. Juba Bouaziz befasst sich mit der Entwicklung völlig neuer Materialien für ultraeffiziente Rechnerarchitekturen. Genauer: Er designt Strukturen für neuromorphes Computing, das die Arbeitsweise des Gehirns nachahmt, und für Quantencomputing, das die Prinzipien der Quantenphysik nutzt. Die neuen Bauelemente basieren nicht mehr auf klassischer Elektronik, sondern auf quantenmechanischen Effekten.
„Meine Methodik besteht darin, klassische Computer als Plattform für die Entdeckung und den Entwurf von Quantenmaterialien zu nutzen. Um Materialien für neuromorphe Bauelemente, z. B. spintronische Synapsen zu entwerfen und zu optimieren, verwende ich einen multiskaligen Ansatz, der Quantensimulationen und maschinelles Lernen kombiniert“, erklärt Bouaziz. „Für Quantencomputing-Anwendungen, z. B. Qubits, bei denen jedes Atom zählt, verwende ich Hochleistungsrechner und groß angelegte Simulationen, die sich auf Hunderttausende von Atomen erstrecken. Meine Forschung wird ein mikroskopisches Verständnis und Designregeln für Quantenmaterialien liefern und damit die Entwicklung energieeffizienter neuromorpher Hardware und skalierbarer Quantencomputing-Technologien unterstützen.“
Die Universität Duisburg-Essen bietet ihm dafür ein wissenschaftlich exzellentes Umfeld: Mit dem Center for Nanointegration Duisburg-Essen (CENIDE), dem Sonderforschungsbereich 1242 zur Nichtgleichgewichtsdynamik in Quantenmaterialien sowie dem Transregio 270 zur Hysterese magnetischer Materialien findet Bouaziz ein breites Spektrum komplementärer Expertise vor. Enge Anknüpfungspunkte bestehen insbesondere zu den Arbeitsgruppen für Dichtefunktionaltheorie, Quantenmaterialien und neuromorphe Gerätekonzepte.
Bouaziz studierte in Algerien Physik und war ab 2014 Wissenschaftler im Forschungszentrum Jülich. 2019 wurde er an der RWTH Aachen promoviert. Anschließend forschte er an der University of Warwick, dem Forschungszentrum Jülich und zuletzt zwei Jahre an der Universität Tōkyō. Er wurde mehrfach ausgezeichnet, unter anderem mit dem Feodor-Lynen-Stipendium der Alexander von Humboldt-Stiftung.
09.12.2025Die Fakultät für Physik trauert um ihren Ehrendoktor Prof. Dr. Siegfried Großmann
Nachruf von Prof. Dr. Stefan Thomae
Am 21. November 2025 starb Professor Siegfried Großmann in Marburg im Alter von 95 Jahren. Mit ihm verlieren wir einen herausragenden Forscher, Lehrer und wissenschaftlichen Ratgeber. Aufgrund seiner hervorragenden wissenschaftlichen Leistungen insbesondere in der Theorie der hydrodynamischen Turbulenz und der nichtlinearen Dynamik verlieh ihm die Fakultät für Physik 2006 die Ehrendoktorwürde.
Siegfried Großmann studierte in Berlin zunächst an der Pädagogischen Hochschule, dann an der Freien Universität und unterrichtete nach dem zweiten Staatsexamen an einem Gymnasium in Berlin Tempelhof. Als ihm nach drei Jahren im Schuldienst eine Assistentenstelle an der FU angeboten wurde, kehrte er an die Universität zurück, promovierte nach einem Jahr mit einer Arbeit über die unelastische Streuung von Wasserstoffmolekülen an Wasserstoff und habilitierte sich nach zwei weiteren Jahren mit einer Arbeit zu quantenmechanischen Transportgleichungen. Nach einer kurzen Zeit als Konservator an der TU München wurde er auf eine Professur an der Philipps Universität Marburg berufen, wo er im Wintersemester 1963/64 zum ersten Mal seine "Hilbertraum-Vorlesung" über Funktionalanalysis hielt.
Sein Forschungsschwerpunkt war die Physik des statistischen Nichtgleichgewichts, die theoretische Beschreibung von Systemen mit vielen Freiheitsgraden, in denen große Fluktuationen auftreten. Unter diesem Gesichtspunkt hat er Supraleiter, Laser, Flüssigkeiten, Gase und Plasmen, chemische Reaktions-Diffusions-Systeme, Schwerionenstöße, zerfallende Atomkerne, turbulente Strömungen und einiges mehr untersucht. Seine Vorlesungen waren bei den Studenten sehr beliebt wegen ihrer Klarheit und seines guten Vortrags und weil man merkte, dass sie ihm selbst Spaß machten. Darüber hinaus war sein Einsatz für die Organisation und Lenkung der Wissenschaft außergewöhnlich. Als Gutachter, Mitglied und Vorsitzender von zahlreichen Kommissionen und als langjähriger Herausgeber von wissenschaftlichen Zeitschriften hat er die Wissenschaftslandschaft, wie wir sie heute vorfinden, mit geprägt.
20.11.2025Gehen ein paar Künstler ins Physiklabor ...
Ausstellung verbindet Welten – Quanten und Kunst
Wenn zwei völlig verschiedene Welten – Kunst und Quantenphysik – aufeinandertreffen, entstehen neue Perspektiven. Das beweist anschaulich das nationale Kunst- und Wissenschaftsprojekt „Quantum meets Arts“. Die Deutsche Physikalische Gesellschaft hat es anlässlich des Quantenjahrs 2025 initiiert, und die UDE ist einer von vier Projektstandorten. Elf Künstler:innen der Rhein-Ruhr-Region zeigen jetzt auf dem Duisburger Campus ihre kreative Auseinandersetzung mit Quantenphänomenen. Die Ausstellung ist ausschließlich am Dienstag, 9. Dezember, zu sehen.
Die Arbeiten umfassen Videos, Skulpturen, Zeichnungen und Fotografien. Für ihre Werke haben sich die Kunstschaffenden in den Laboren der UDE-Quantenoptik und durch Gespräche mit den Wissenschaftler:innen inspirieren lassen. Barbara Koxholt etwa zeigt Fotografien von ganz alltäglichen Dingen und Orten, in denen sich „Doppelspalten“ finden. Damit spielt sie augenzwinkernd auf das berühmte Experiment an, das zeigt, dass Licht sich wie eine Welle verhält. Dagegen greift Andreas Reichert mit seiner Skulptur „Granitscheibe“ (s. Bild) die Form eines Orbitals in einem Atom auf. Während man früher dachte, Elektronen kreisen in festen Bahnen um die Atomkerne, weiß man heute: Sie halten sich in bestimmten Bereichen mit einer gewissen Wahrscheinlichkeit auf.
Die beteiligten Künstler:innen sind neben Barbara Koxholt und Andreas Reichert außerdem Stacey Blatt, Christina Böckler, Susan Feind, Martin Gensheimer, Elisabeth Höller, Luise Hoyer, Kerstin Müller-Schiel, Sigrid Neuwinger und Peter Steinebach.
Video der Veranstaltung von Nicolas Wöhrl
Wann: Dienstag 9. Dezember 2025, von 10 bis 19 Uhr
Öffentlicher Empfang: 17 Uhr
Wo: Foyer des Hörsaals MC, MC-Gebäude, Campus Duisburg
Weitere Informationen: stacey.blatt@uni-due.de
20.11.2025Zwei Minuten Schwerelosigkeit - Team aus der AG Wurm bewirbt sich um Raketenflug für ihr Experiment
Ein Team aus der Forschungsgruppe von Prof. Dr. Gerhard Wurm ist am Montag und Dienstag, dem 24. und 25.11.2025, zu einem Workshop beim DLR in Bonn eingeladen - Christopher Grünebeck, Kai Stuers, Nico Wenders und Gretha Swantje Völke.
Mit einem 25-minütigen Vortrag bewerben sie sich um einen Raketenflug für ihr Experiment. Sie sind bereits in die Endrunde gekommen. Das Ziel besteht darin, das magnetische Wachstum von Protoplaneten zu erforschen, indem eisenhaltige oder sogar normale Eisenkugeln unter Schwerelosigkeit einem Magnetfeld von wenigen mT ausgesetzt werden. Die Schwerelosigkeit wird für zwei Minuten anhalten.
Voraussichtlicher Startzeitpunkt ist der Frühling 2027, wobei wir als Team dann für zwei Wochen nach Kiruna fahren und den Start betreuen würden.
MAVERICK: Ein neuer Blick auf die Entstehung von Planeten Wie entstehen eigentlich Planeten? Aus winzigen Staubkörnern bilden sich nach und nach größere Klumpen – bis schließlich ganze Himmelskörper entstehen. Doch dieser Prozess stößt früh an Grenzen: Allein durch Zusammenstöße wachsen Teilchen nicht beliebig weiter. Genau hier setzt das Projekt MAVERICK der Universität Duisburg-Essen an.
Das Team untersucht eine Frage, die in der Forschung bisher kaum Beachtung fand: Welche Rolle spielen magnetische Felder bei der Entstehung der ersten festen Strukturen im All? In den Regionen, in denen junge Planeten entstehen, sind solche Felder allgegenwärtig. Ob und wie sie Staubteilchen zusammenhalten oder ihr Wachstum beeinflussen, ist jedoch weitgehend ungeklärt.
Um dies herauszufinden, will MAVERICK die Stabilität von magnetisch verbundenen Teilchenansammlungen unter Weltraumbedingungen testen. Entscheidend ist, wie groß solche Aggregate maximal werden können und welche Faktoren darüber bestimmen, wann sie wachsen – und wann sie wieder zerfallen. Für dieses Vorhaben nimmt das Projekt an der Auswahlrunde der REXUS 37/38 Raketen-Kampagne teil. Ein suborbitaler Raketenflug bietet ideale Bedingungen, um die Teilchen im Zustand der Schwerelosigkeit zu beobachten und ihre Entwicklung präzise zu messen.
Das Team sucht derzeit noch Unterstützerinnen und Unterstützer sowie wissenschaftliche Partner, die das Projekt begleiten möchten. Interessierte können sich direkt an MAVERICK wenden, um mehr über das Experiment zu erfahren und die Forschung zur frühen Planetenentstehung mit voranzutreiben.
18.11.2025Experimentieren, staunen, verstehen – Nacht der Physik in Duisburg
von Juliana Fischer
Bei der Nacht der Physik an der Universität Duisburg-Essen darf wieder nach Herzenslust geforscht, gebaut und gestaunt werden. Am 21. November ab 17 Uhr öffnet die Fakultät für Physik am Campus Duisburg (Lotharstraße 1) ihre Türen. Kinder und Erwachsene können bis 23 Uhr Experimente ausprobieren, Labore besichtigen und entdecken, wie spannend Wissenschaft im Alltag sein kann. Der Eintritt ist frei, eine Anmeldung nicht nötig.
Mit Experimenten, Laborführungen und Vorträgen wecken die Forschenden der UDE Neugier und Begeisterung für Physik: Im „schnellsten Labor der Welt“, dem Schullabor des Sonderforschungsbereichs 1242, wird Licht zum Werkzeug – Laserstrahlen stoppen die Zeit, Lichtblitze messen Sekundenbruchteile, und im Laserlabyrinth darf mitgespielt werden. Darüber hinaus können Kinder ab zehn Jahren selbst handwerklich aktiv werden: Sie greifen zu Kabel, Draht und Schraubenzieher und verwandeln eine einfache Bürste im Handumdrehen in ein kleines Rennfahrzeug oder bauen ein solarbetriebenes Spielzeugauto.
Den ganzen Abend über öffnen die Forschungslabore ihre Türen: Im Reinraum lässt sich verfolgen, wie aus Halbleitern winzige Computerchips entstehen – von der Lithografie bis zu ultradünnen Materialien. Andere Experimente führen ins All: Wie aus mikroskopisch kleinen Staubkörnchen Planeten wachsen, zeigen Versuche zu Gravitation und Schwerkraft. Und wer wissen will, wie man Elektronen in Bewegung bringt, erlebt bei der Führung „Mit Terahertz-Strahlung auf Elektronenjagd“, wie Infrarotstrahlen unsichtbare Teilchen sichtbar machen.
Ab 19 Uhr beleuchten Physiker der UDE in Vorträgen die Kernthemen der Physik – vom All bis zur Quantenwelt. Dr. Jens Teiser erklärt, warum auf dem Mond die Sanduhr stehen bleibt, Prof. Dr. Axel Lorke und Prof. Dr. Klaus Hornberger entführen in die Welt des diesjährigen Physik-Nobelpreises. Danach wird’s alltagsnah: Dr. Florian Mazur spricht über die Optimierung von Flughäfen, Prof. Dr. Hendrik Härtig über politische Bildung im Physikunterricht.
Wer nach dem Staunen selbst ins Studium starten möchte, findet im Foyer Ansprechpartner:innen zu Physik, Lehramt Physik und Energy Science. Lehrende und Studierende berichten aus ihrem Alltag, erklären das Buddy-System und beantworten Fragen zu Bewerbung, Studienverlauf und Berufsperspektiven – ganz ohne Formeln, aber mit viel Begeisterung.
Die Veranstaltung ist auch mit Rollstuhl, Rollator oder Kinderwagen zugänglich.
17.11.2025Wie fühlt sich ein Physikstudium an? Das Probestudium Physik gibt einen guten Einblick!
53 Schülerinnen und Schüler haben am 8. November 2025 mit Ihrem Probestudium in unserer Fakultät für Physik begonnen. Am 14. März 2026, nach 15 Terminen – immer samstags, werden sie genau wissen, ob sie bei uns ein reguläres Studium der Physik, ein Lehramtsstudium Physik oder ein Studium Energy Science starten werden.
Das Probestudium befasst sich mit dem Thema Schwingungen und Wellen. Dazu werden experimentelle und theoretische Vorlesungen angeboten, sowie Übungen und ein Praktikum. Seit 25 Jahren bietet die Fakultät für Physik an der Universität Duisburg-Essen diese Möglichkeit an, sich ein objektives Bild vom Studium zu machen. In diesem Umfang einzigartig in Deutschland. Grund genug für einige Probestudierende, mehr als hundert Kilometer Anfahrt in Kauf zu nehmen.
Dr. Ana Vila-Verde starte die Reihe mit drei Vorlesungen zur Mathematik für Physiker:innen.
13.11.2025Hertha-Sponer-Preis 2026 – Physikerin Maria Azhar geehrt
von Cathrin Becker
Wenn es um magnetische Muster in Materialien geht, ist sie eine absolute Expertin: Für ihre Forschung im Bereich Topologie im Magnetismus wird Dr. Maria Azhar mit dem Hertha-Sponer-Preis der Deutschen Physikalischen Gesellschaft geehrt. Die Jury hob besonders die große Originalität hervor, mit der die Physikerin der Universität Duisburg-Essen wichtige Beiträge zum Verständnis komplexer Spinstrukturen in magnetischen Materialien geleistet hat.
Dr. Maria Azhar studierte Physik in Islamabad und schloss anschließend das „Top Master Nanoscience“-Programm an der Universität Groningen ab. Im Anschluss promovierte sie dort bei Prof. Maxim Mostovoy zu nichtkollinearem Magnetismus. Zudem forschte sie als wissenschaftliche Mitarbeiterin am Karlsruher Institut für Technologie bevor sie im August 2023 als Postdoktorandin an die UDE wechselte.
Hier setzt sie in der Arbeitsgruppe „TWIST – Topological Whirls In SpinTronics“ von Prof. Karin Everschor-Sitte ihre ausgezeichnete Forschungsarbeit im Bereich topologische 3D-Magnetstrukturen fort, die das Verständnis der Topologie im Magnetismus, komplexer magnetischer Phasen und ihrer möglichen Anwendungen weiter vorangebracht hat.
Dafür und für weitere Forschungsleistungen wurde sie nun von der Jury des Hertha-Sponer-Preises gelobt: Maria Azhar habe bereits während ihrer Promotion grundlegende Einsichten in den nichtkollinearen Magnetismus geliefert und in weiteren Arbeiten Schraubenversetzungen in Helimagneten vorhergesagt. „Jüngst trug sie wesentlich zur topologischen Klassifizierung dreidimensionaler magnetischer Strukturen bei, die die internationale Entwicklung des Feldes prägen“, heißt es in der Jurybegründung.
Der Hertha-Sponer-Preis wird für hervorragende wissenschaftliche Arbeiten auf dem Gebiet der Physik an eine Wissenschaftlerin vergeben. Der Preis soll vor allem jüngere Wissenschaftlerinnen durch öffentliche Auszeichnung ermutigen und so mehr Frauen für die Physik gewinnen. Die Auszeichnung besteht aus einem Preisgeld von 3.000 Euro und einer Urkunde.
Dr. Maria Azhar wird beides am 17. März 2026 während der 89. Jahrestagung der Deutschen Physikalischen Gesellschaft in Erlangen feierlich verliehen.
16.10.2025Wenn Störungen nützlich werden – Quantenrauschen im Tunneleffekt gezähmt
von Jennifer Meina
Was normalerweise als Störung gilt, kann unter bestimmten Bedingungen erstaunlich nützlich sein: Rauschen. Forschende der Universität Duisburg-Essen haben gezeigt, wie sich das zufällige Rauschen, das der quantenmechanische Tunneleffekt verursacht – ein Phänomen, das auch im Mittelpunkt des diesjährigen Physik-Nobelpreises steht –, gezielt beeinflussen lässt. Die nun in Communications Physics veröffentlichten Ergebnisse eröffnen neue Perspektiven für zukünftige Quantenbauelemente.
Der HiFi-Enthusiast hasst es, Elektroniker:innen macht es die Arbeit schwer: Rauschen - also ungewollte, zufällige Störungen aus der Umgebung, die das eigentliche Signal überlagern und verfälschen. Rauschen kann aber auch nützlich sein und Prozesse verstärken. Der dahintersteckende Mechanismus ist die „Stochastische Resonanz“. Bei diesem Phänomen verstärken kleine zufällige Schwankungen ein eigentlich schwaches Signal, so dass es klarer und regelmäßiger wahrgenommen werden kann.
In einer Kooperation aus Experiment und Theorie ist es den Arbeitsgruppen um Prof. Dr. Axel Lorke und Prof. Dr. Jürgen König an der Universität Duisburg-Essen (UDE) nun gelungen, Stochastische Resonanz in einem Quantenphänomen zu beobachten. Mithilfe von hochauflösender Laserspektroskopie haben die Arbeitsgruppen die Bewegung eines einzelnen Elektrons verfolgt, das sich entweder in einer winzigen Nanostruktur (einem „Quantenpunkt“) befinden kann oder außerhalb in einem Elektronenreservoir. Zwischen Reservoir und Quantenpunkt gibt es eine Barriere, die das Elektron aber aufgrund des quantenmechanischen Tunneleffekts durchdringen kann. „Wenn man einen Ball gegen eine Barriere wirft, wird er zurückprallen. In der Quantenwelt kann aber ein Elektron mit einer bestimmten Wahrscheinlichkeit die Barriere durchdringen und so auf die andere Seite gelangen. Das ist möglich, weil Teilchen sich auch wie Wellen verhalten. Das ist der Tunneleffekt“, erklärt Lorke.
Der Tunnelprozess, dessen Erforschung mit dem diesjährigen Nobelpreis ausgezeichnet wurde, ist vollkommen zufällig und stellt damit eine Rauschquelle für die Elektronenbewegung dar. Durch Anlegen einer kleinen Wechselspannung konnte diese Zufallsbewegung aber gebändigt werden, so dass das Elektron deutlich regulärer zwischen Quantenpunkt und Elektronenreservoir hin- und her pendelte.
Um dies zu zeigen, wurden mithilfe von hochentwickelten statistischen Methoden Millionen von Tunnelprozessen zeitlich analysiert. Überraschend dabei: Die beste Unterdrückung der Zufallsbewegung tritt nicht bei der Frequenz auf, die nach den üblichen Erklärungen der Stochastischen Resonanz zu erwarten gewesen wäre. Je nach Stärke der Wechselspannung lag sie zum Teil sogar deutlich darunter. Ein Phänomen, das noch nicht vollständig verstanden ist und die Tür zu weiteren Untersuchungen aufstößt.
Die Arbeit der Duisburger Physiker ist von Relevanz für visionäre Quantenbauelemente, beispielsweise für abhörsichere Kommunikationskanäle, in denen die einzelnen Bits möglichst regelmäßig verschickt werden sollen.
Im Bild: Die Arbeitgruppen (hier Doktorand Hendrik Mannel) erforschten mithilfe von Laserspektroskopie, wie Rauschen den Tunneleffekt beeinflusst.
16.10.2025Forschende erzeugen leitfähige Grenzfläche in Nickelat-Materialien – Lichtschalter für Elektronen
von Juliana Fischer
Mit UV-Licht lässt sich an der Grenzfläche zweier Oxidmaterialien ein extrem leitfähiger Zustand gezielt ein- und ausschalten – und das in Sekundenschnelle. Dieser neu entdeckte „Lichtschalter für Elektronen“ markiert einen Meilenstein auf dem Weg zu lichtgesteuerter Elektronik und könnte künftig auch in der Supraleitung Anwendung finden. Das Fachmagazin Nature Materials berichtet. Teil des internationalen Teams sind die theoretische Physikerin Prof. Dr. Rossitza Pentcheva (Universität Duisburg-Essen) und ihr ehemaliger Mitarbeiter Dr. Benjamin Geisler (University of Florida).
„Der Clou unserer Arbeit ist, dass sich ein außergewöhnlich leitfähiger Zustand allein mit Licht ein- und ausschalten lässt – fast wie mit einem Schalter“, sagt Prof. Dr. Rossitza Pentcheva, theoretische Physikerin an der Universität Duisburg-Essen (UDE). „Damit eröffnen sich auch neue Möglichkeiten, die Supraleitung in Nickelaten künftig gezielt durch ultraschnelle Lichtimpulse zu beeinflussen.“
Im Mittelpunkt der Studie steht NdNiO₂, ein Vertreter der sogenannten infinite-layer Nickelate. Diese Materialklasse ähnelt den Kupferoxid-Hochtemperatursupraleitern und hat in den letzten Jahren an Bedeutung gewonnen, da sie unter bestimmten Bedingungen selbst supraleitend werden kann.
Geisler und Pentcheva hatten bereits 2020 vorhergesagt, dass sich an der Grenzfläche zwischen dem Nickelat NdNiO₂ und dem Isolator Strontiumtitanat (SrTiO₃) ein sogenanntes zweidimensionales Elektronengas bilden könnte – eine extrem dünne Schicht, in der sich Elektronen nahezu reibungslos bewegen. Solche Zustände gelten als Schlüssel für künftige Entwicklungen in der Nanoelektronik, Spintronik und Quanteninformation. In bisherigen Experimenten blieb das Elektronengas jedoch aus, weil sich die Atome an der Grenzfläche stärker vermischten als erwartet – wie eine frühere gemeinsame Arbeit der Universitäten Cornell, Stanford und Duisburg-Essen in Nature Materials bereits 2023 gezeigt hatte.
Nun nutzte das internationale Forschungsteam gezielt Licht als Stimulus: In den Experimenten bestrahlten sie die Grenzfläche mit ultraviolettem Licht und maßen gleichzeitig die elektrische Leitfähigkeit. Parallel dazu führten Geisler und Pentcheva auf dem Supercomputer der UDE quantenmechanische Simulationen durch, mit denen sich das Verhalten der Elektronen präzise beschreiben ließ.
„Wird das Licht eingeschaltet, verändert sich das Material schlagartig: Der elektrische Widerstand sinkt um bis zu ein Hunderttausendfaches – die Probe leitet plötzlich rund 100.000-mal besser“, erklärt Pentcheva. Möglich macht das ein winziges elektrisches Feld an der Grenzfläche, das die durch UV-Licht freigesetzten Elektronen wie auf einer unsichtbaren Schiene in einer hauchdünnen Schicht sammelt. Dort können sie sich besonders leicht bewegen und bilden das leitfähige Elektronengas. Sobald das Licht ausgeschaltet wird, verschwindet dieser Zustand wieder vollständig – das Material kehrt in seinen Ausgangszustand zurück.
Im Bild: Licht an – Strom an: UV-Strahlung verwandelt die Grenzfläche des Materials in eine hochleitfähige Elektronenschicht (Illustration mit KI generiert).
07.10.2025Magnetschwebebahn unseres CRC/TRR 270 wird im Rahmen des Fernsehformats „Die beste Klasse Deutschlands“ gezeigt
Magnetforscher von der Universität Duisburg-Essen haben das Superfinale von "Die beste Klasse Deutschlands" (11.10.2025 um 8:20 Uhr im Ersten) mit einem Experiment unterstützt. Die gezeigte Magnetschwebebahn demonstriert die Levitation von einem Supraleiter über einer Bahn aus Permanentmagneten. Das Experiment wurde im Zuge des DFG-geförderten Projekts SFB//TRR 270 HoMMage gebaut, um Forschung auch einer breiten Öffentlichkeit zu vermitteln. Dr. Nicolas Josten aus der Arbeitsgruppe von Professor Michael Farle fuhr dafür zum Studiopark KinderMedienZentrum nach Erfurt um Bavaria Entertainment bei den Dreharbeiten zur unterstützen. Die Show wird von Clarissa Corrêa da Silva und Tobias Krell moderiert und zeigt den Wettbewerb dreier Schulklassen um den Titel der besten Klasse Deutschlands.
09.10.2025Artikel in Nature Astronomy bestätigt Theorie – Seltenes Siebenfach-Sternsystem entdeckt
von Jennifer Meina
Es ist ein äußerst seltenes Phänomen im Weltall: Ein System aus gleich sieben jungen Sternen. Einem internationalem Forschungsteam unter Mitwirkung von Prof. Dr. Rolf Kuiper von der Universität Duisburg-Essen gelang diese Entdeckung. Die Ergebnisse veröffentlichte das Team nun in der renommierten Fachzeitschrift Nature Astronomy. Sie liefern eine Erklärung, warum die Instabilität der Gasscheiben für die Entstehung dieser Mehrfachsysteme entscheidend sind.
Stellare Mehrfachsysteme sind in der Astronomie von großer Bedeutung: Sie können zum einen zu astronomischen Phänomenen führen – etwa Röntgendoppelsternen, Gammastrahlenausbrüche, Supernovae und Sternverschmelzungen, die wichtige Quellen für Gravitationswellen sind. Zum anderen beeinflussen sie die Dynamik von Sternhaufen.
„Das sind große Gruppen von Sternen, die aus derselben Gas- und Staubwolke entstanden sind und durch die Gravitation aneinander gebunden bleiben. Dabei sind alle Sterne in einem Haufen etwa gleich alt und haben eine ähnliche chemische Zusammensetzung“, erklärt Prof. Dr. Rolf Kuiper, Leiter der Arbeitsgruppe für numerische Astrophysik an der Universität Duisburg-Essen (UDE). Das neu entdeckte System, dessen Sterne sich derzeit noch bilden, befindet sich in der Sternentstehungsregion NGC 6334I(N) – einem besonders aktiven Teil des sogenannten „Katzenpfotennebels“, in dem gerade viele massereiche Sterne „geboren“ werden.
Doch wie Systeme mit vielen Sternen überhaupt entstehen, war bisher kaum verstanden. Die Stabilitätsanalyse der Forschenden zeigt nun: Die Gasscheibe, die das Siebenfach-System enthält, ist dynamisch instabil. Das bedeutet, die Schwerkraft innerhalb der Scheibe wirkt stärker als die Kräfte, die sie eigentlich stabil halten könnten (z. B. Rotation oder Druck). Dadurch „bricht“ die Scheibe auseinander in einzelne Fragmente, die sich jeweils zu Sternen verdichten können. „Unsere Beobachtungen zeigen erstmals eindeutig, dass eine zerbrechende, instabile Gasscheibe tatsächlich mehrere Sterne gleichzeitig hervorbringen kann. Nun können wir einen Mechanismus bestätigen, der zuvor nur in Theorien vermutet wurde und wir können unsere Arbeit nun gezielter vertiefen“, erklärt der Astrophysiker.
Grafik: In der rotierenden Gasscheibe haben sich sieben junge Sterne gebildet. Das außergewöhnliche System liefert neue Einblicke in die Entstehung hochkomplexer Sternsysteme.
Weitere Informationen:
Die Studie finden Sie hier.
Prof. Dr. Rolf Kuiper, Arbeitsgruppe für Numerische Astrophysik, rolf.kuiper@uni-due.de
07.10.2025Atreya Majumdar erhält Add-on Fellowship der Joachim Herz Stiftung – Förderung für herausragende Nachwuchsforschung
Atreya Majumdar aus der Arbeitsgruppe von CENIDE-Mitglied Prof. Dr. Karin Everschor-Sitte wurde für das Jahr 2025 in das „Add-on-Stipendium für interdisziplinäre Wissenschaft und Transfer” der Joachim-Herz-Stiftung aufgenommen. Die Auszeichnung wird an junge Nachwuchswissenschaftler vergeben, deren Arbeit an der Schnittstelle verschiedener Disziplinen ein hohes Potenzial und gesellschaftliche Relevanz verspricht.
Das Stipendienprogramm fördert exzellente Wissenschaftlerinnen und Wissenschaftler aus den Wirtschafts-, Lebens- und Ingenieurwissenschaften. Über einen Zeitraum von zwei Jahren erhalten die Stipendiatinnen und Stipendiaten eine finanzielle Unterstützung von bis zu 15.000 Euro für ihre Forschung sowie Zugang zu einem exklusiven wissenschaftlichen Netzwerk. Ein wesentlicher Bestandteil des Programms sind auch Weiterbildungsmöglichkeiten, die speziell den Transfer wissenschaftlicher Erkenntnisse in Gesellschaft und Wirtschaft stärken.
Die Auswahl von Atreya Majumdar unterstreicht die hohe Qualität und zukunftsweisende Ausrichtung seiner Arbeit. Die Unterstützung durch die Joachim Herz Stiftung ermöglicht es ihm, seine vielversprechende Forschungsarbeit weiter voranzutreiben und durch interdisziplinären Austausch neue Perspektiven zu gewinnen.
Ein zentrales Ziel der Förderung durch die Joachim Herz Stiftung ist die Stärkung der wissenschaftlichen Unabhängigkeit vielversprechender Forscher. Der gezielte Austausch über Fachgrenzen hinweg ermöglicht den Stipendiaten einen tieferen Einblick in verwandte Disziplinen, was innovative, interdisziplinäre Forschungsansätze stärken soll
02.10.2025Aktionstag „Türen auf mit der Maus“ – SpielZeit an der UDE
von Birte Vierjahn
Ins Labor linsen? Gar hineingehen? Anfassen erlaubt? Aber bitte! Am 3. Oktober beteiligt sich die Universität Duisburg-Essen mit vier Stationen am bundesweiten Maus-Türöffner-Tag, der in diesem Jahr unter dem Motto „SpielZeit“ steht. Schon kurz nach Freigabe der Anmeldung waren alle Plätze für die Angebote in Duisburg und Essen vergeben.
Wenn am 3. Oktober bundesweit Türen für die „Sendung mit der Maus“ aufgehen, ist die Universität Duisburg-Essen (UDE) vierfach dabei: Wissenschaftler:innen der Ingenieurwissenschaften und der Physik (Duisburg), der Technischen Chemie, des 3D-Druck-Labors des Co-Creation Lab Produktinnovationen sowie des Erwin L. Hahn-Instituts für Magnetresonanztomografie (Essen) erklären Kindern, Jugendlichen und Erwachsenen, wie spannend ihre Forschung ist.
Eigene Schiffe bauen und lernen, wie stark Stahl wirklich ist, mit Atomen spielen, kleine Wasserstoffautos gegeneinander antreten lassen, eine Schnitzeljagd durch das 3D-Druck-Labor machen, zugucken, wie das Gehirn denkt und den stärksten Magneten des Ruhrgebiets kennenlernen – viele engagierte Mitarbeiter:innen in Fakultäten, (An-)Instituten, Laboren und Werkstätten machen den Feiertag zur SpielZeit.
Der Aktionstag „Türen auf mit der Maus“ findet jährlich am 3. Oktober statt; dieses Mal öffnen mehr als 850 Einrichtungen bundesweit ihre Türen.
23.09.2025Konzert zu 100 Jahren Quantenmechanik – „Ein Quantum Musik“
von Jennifer Meina
Quantenphysik und Musik – passt das zusammen? Sehr gut sogar, wenn es nach der Bläsersymphonie der Abtei Hamborn und den Physikern der Universität Duisburg-Essen, Dr. Nicolas Wöhrl und Prof. Dr. Axel Lorke, geht. Am Sonntag, 5. Oktober, kann sich jede:r selbst ein Bild davon machen. Dann findet das Konzert „Ein Quantum Musik – Musik trifft Wissenschaft im Quantenjahr 2025“ in Duisburg statt. Begleitet wird das Programm von verblüffenden Experimenten, die die Quantenwelt lebendig werden lassen.
Computer, Solarzellen, Laser – viele Errungenschaften unserer Zeit beruhen auf der Quantenmechanik. Vor rund 100 Jahren begann die Entdeckung dieser faszinierenden Welt der Atome und Lichtteilchen, in der Wahrscheinlichkeiten und Unschärfen die klassischen Vorstellungen von Naturgesetzen ablösen.
Passend zu dieser nur scheinbar „unscharfen“ Physik erwartet die Besucher:innen am Konzertabend ein Programm voller Energie und Farben: impulsive Rhythmen und schillernde Klänge entführen in die sichtbare und unsichtbare Quantenwelt. Wie sieht diese aus? Und was hat sie mit unserem Alltag zu tun? Musikalisch nähert sich die Bläsersymphonie der Abtei Hamborn diesen Fragen mit eigens arrangierten Stücken – aber auch mit beliebten Melodien, etwa aus Aladdin oder Star Wars.
Wissenschaftlich führen Prof. Dr. Axel Lorke und Dr. Nicolas Wöhrl durch das Programm. Mit anschaulichen Experimenten und einer Prise Humor geben die beiden Physiker der Universität Duisburg-Essen (UDE) einen Einblick in die Quantenphysik. Vorkenntnisse sind dabei nicht nötig – Neugier genügt.
Datum: Sonntag, 5. Oktober, ab 18 Uhr
Ort: Altes Audimax Campus Duisburg, Gebäude LA, Lotharstr. 65
Karten: print@home oder auch an der Abendkasse
Weitere Informationen:
https://blaesersymphonie.de/konzertinfos/
https://www.quantum2025.de
Dr. Nicolas Wöhrl, Experimentalphysik, Tel. 0203/379-3131, nicolas.woehrl@uni-due.de
Redaktion: Jennifer Meina, Tel. 0203/379-1205, jennifer.meina@uni-due.de
13.08.2025Dr. Katharina Ollefs tritt Professur an der Universität Heidelberg an
Die Fakultät für Physik gratuliert Katharina Ollefs zur W3-Professur für Festkörperphysik an der Universität Heidelberg. Sie hat ihre Stelle am 1. August 2025 angetreten. Katharina Ollefs studierte von 2003 bis 2008 Physik in unserer Fakultät und wurde 2012 in der Forschungsgruppe von Prof. Dr. Michael Farle promoviert. Katharina Ollefs war Projektleiterin im SFB/TRR 270 HoMMage und ab 2020 nicht nur Projektleiterin beim SFB 1242, sondern auch noch Vorstandsmitglied. Das hat sie erfreulicherweise nicht davon abgehalten, zwei Kinder zu bekommen.
Wir wünschen ihr alles Gute!
31.07.2025Basketball U20-Nationalteam und Physikstudium parallel? Maja Manten meistert diese Herausforderung!
Die Physikstudentin Maja Manten spielt am Samstag, dem 2. August 2025, im U20-Nationalteam bei der Basketball-Europameisterschaft in Portugal. Die Vorbereitungen dafür sowie das Spielen als Center-Spielerin des Zweitligisten New Basket Oberhausen hindern sie nicht am Physikstudium. Gerade hat sie bei Prof. Dr. Frank Meyer zu Heringdorf ihre Bachelorarbeit abgegeben – wohlgemerkt – sie ist noch im U20-Team! „Die größte Herausforderung ist definitiv das Zeitmanagement – Training, Spiele und Lehrveranstaltungen unter einen Hut zu bringen, erfordert eine gute Planung.“ Viele Professorinnen und Professoren zeigen offenbar Verständnis für ihre Situation. „Sie ermöglichen mir zum Beispiel, Veranstaltungen mit Anwesenheitspflicht flexibel zu gestalten oder den Start meiner Bachelorarbeit an den Sommer mit der Nationalmannschaft anzupassen.“ Bleibt nur noch, ihr viel Spaß und Erfolg zu wünschen!
30.07.2025Prof. Dr. Gerhard Wurm übernimmt die Leitung der Fakultät für Physik
Prof. Dr. Gerhard Wurm wurde vom Fakultätsrat zum neuen Dekan der Fakultät für Physik gewählt und übernimmt dieses Amt am 1. August 2025. Nach einer Amtszeit von 18 Jahren und 7 Monaten geht sein Vorgänger, Prof. Dr. Michael Schreckenberg, in den Ruhestand. Er war damit der dienstälteste Dekan in der Geschichte der UDE. Gerhard Wurm ist seit dem 15. Oktober 2009 Professor für Experimentelle Astrophysik an unserer Fakultät und hat bereits mehrere Jahre als Prodekan Erfahrung gesammelt. Zu seinem Nachfolger als Prodekan wurde Prof. Dr. Jürgen König gewählt. Prof. Dr. Michael Horn-von Hoegen als weiterer Prodekan und Prof. Dr. Hermann Nienhaus als Studiendekan bleiben im Amt.
28.07.2025Neu in unserer Fakultät für Physik: Dennis Meier Energiesparen mit intelligenten Materialien
von Dr. Alexandra Nießen
Energieeffizient und mit neuester Technik unterwegs: Was sogenannte ferroische Materialien dazu beitragen können, erforscht Prof. Dr. Dennis Meier im Research Center „Future Energy Materials and Systems“ der Universitätsallianz Ruhr. Zum ersten Juli 2025 hat er die Professur für Funktionale Ferroische Systeme an der Fakultät für Physik der Universität Duisburg-Essen angenommen. Der international anerkannte Experte ist führend in der Forschung zu funktionalen Domänenwänden und Spin-Texturen. Er untersucht, wie sich die winzigen Strukturen im Inneren von Funktionsmaterialien gezielt für neuartige Technologien einsetzen lassen.
Ferroische Materialien begegnen uns im Alltag häufiger, als man denkt – und sie sind technologisch äußerst vielseitig: „Unser Team erforscht spezielle Materialien mit elektrischen und/oder magnetischen Eigenschaften – sogenannte ferroische Materialien –, die auf äußere Reize wie elektrische oder magnetische Felder besonders empfindlich reagieren. Solche Materialien weisen Bereiche mit geordneten Strukturen auf, sogenannte Domänen, deren Grenzen man als funktionale Domänenwände bezeichnet. Diese Domänenwände sowie sogenannte Spin-Texturen – fein strukturierte magnetische Muster auf kleinstem Raum – zeigen oft außergewöhnliche physikalische Eigenschaften, die sich gezielt für neue Anwendungen nutzen lassen“, erläutert Prof. Dr. Dennis Meier, neuberufener Professor für Funktionale Ferroische Systeme an der Fakultät für Physik an der Universität Duisburg-Essen (UDE).
Diese besonderen Eigenschaften bleiben auch im Kleinstmaßstab erhalten, was sie ideal für die Miniaturisierung macht. Deshalb kommen sie in vielen modernen Technologien zum Einsatz – etwa in Smartphones, Speicherchips oder kabellosen In-Ear-Kopfhörern. Kurz gesagt: Ohne ferroische Materialien wären viele kompakte, leistungsstarke Geräte, die heute selbstverständlich erscheinen, nicht denkbar. „Aufbauend auf unserer bisherigen Forschung ist das Ziel unserer Arbeit, diese Effekte mithilfe modernster Mikroskopie- und Nanostrukturierungstechniken bis auf Atomebene zu untersuchen und zu kontrollieren. Damit schaffen wir die Grundlage für neuartige, energieeffiziente Informations- und Sensortechnologien der Zukunft“, ergänzt Professor Meier.
Um diese Materialien zu erforschen, nutzt sein Team hochauflösende Mikroskopieverfahren wie etwa die Rastersonden- und Elektronenmikroskopie. Durch fokussierte Ionenstrahlen kann es gezielt nanoskalige Strukturen verändern oder erzeugen. Durch die Weiterentwicklung hochpräziser Spezialmikroskopie möchte Professor Meier ins Innere der Materialien schauen. „Wir leisten damit einen wichtigen Beitrag zur Entwicklung, Charakterisierung und Anwendung neuartiger Energiematerialien und beschreiten konzeptionell neue Wege für energiesparende Informationsverarbeitung und Sensorik“, so der 45-Jährige.
„Wenn man auf atomarer Skala Quantenmaterialien so zusammenbaut, dass sie neuartige und einzigartige Eigenschaften zeigen, erschließt man mit exzellenter Grundlagenforschung aus der Physik in den spektakulären Bereichen Spintronics und Topologische Systeme gänzlich neue, wichtige Technologien und Anwendungsfelder. Das führt uns in die Zukunft, und wir sind stolz, für die Universitätsallianz Ruhr und die Universität Duisburg-Essen diesen Spitzenforscher gewonnen zu haben“, sagt Prof. Dr. Barbara Albert, Rektorin der Universität Duisburg-Essen.
Für seine Forschung wurde Meier vielfach ausgezeichnet – unter anderem mit einem ERC Consolidator Grant des European Research Council (2019), dem Gustav-Hertz-Preis der Deutschen Physikalischen Gesellschaft (2017) sowie mehreren Preisen der norwegischen Wissenschaftswelt.
Nach seinem Physikstudium an der Universität Köln (2000-2006) forschte Dennis Meier an der Universität Bonn, wo er 2010 am Helmholtz-Institut für Strahlen- und Kernphysik promoviert wurde. Danach ging er 15 Jahre an drei Hochschulen ins Ausland: von 2010 bis 2013 als Feodor-Lynen-Fellow der Alexander von Humboldt-Stiftung an die University of California, Berkeley (USA) und von 2013 bis 2016 als Leiter einer Nachwuchsgruppe an die ETH Zürich (Schweiz), wo er auch seine Habilitation erlangte. Vor seiner Berufung an die Universität Duisburg-Essen war er Professor an der Technisch-Naturwissenschaftlichen Universität in Trondheim, Norwegen.
21.07.2025Gefragte Expertise – DFG beruft Marika Schleberger in Ausschüsse
- von Ulrike Eichweber
Ihre Expertise ist überzeugend: Die Deutsche Forschungsgemeinschaft (DFG) berief jetzt UDE-Physikerin Prof. Dr. Marika Schleberger in den Senats- und in den Bewilligungsausschuss für die Graduiertenkollegs (GRKs).
Schleberger, die seit 2022 an der UDE (damals noch Universität/Gesamthochschule Essen) forscht und lehrt, wird den Gremiem ab dem 1. Januar 2026 angehören. Insgesamt sind 39 Wissenschaftler:innen in Personalunion Mitglied in beiden Ausschüssen. Künftig entscheidet die Experimentalphysikerin also mit, welche Anträge die DFG in ihrem GRK-Förderprogramm genehmigt. Sie ist langjährige stellvertretende Sprecherin des Graduiertenkollegs des Sonderforschungsbereichs 1242 der UDE und im Vorstand der International Research Training Group 2D-Mature, an dem die UDE beteiligt ist.
"GRKs sind für Universitäten von strategischer Bedeutung, denn sie spiegeln aktuelle Forschungsschwerpunkte wider", erklärt Schlebeger. "Wichtig finde ich, dass es spezifisch abgestimmte Programme gibt, die den Promovierenden exzellente Forschung und Qualifizierung ermöglichen, ohne sie zeitlich zu überfordern." Nun freue sie sich darauf, auch GRKs aus anderen Fachdisziplinen kennenzulernen.
21.07.2025FISU World Conference – Infostände mit Experimenten auf dem König-Heinrich-Platz
Direkt vor dem Theater auf dem König-Heinrich-Platz im Duisburger Stadtzentrum stand am 21. Juli 2025 nicht nur ein Schwimmbecken und eine Strandbar, sondern auch eine Menge interessanter Infostände. Die Fakultät für Physik inklusive des SFB 1242 war mit einigen Experimenten vor Ort, darunter ein Brunnen, bei dem die Tropfen nach oben zu fallen schienen. Zusätzlich gab es eine interessante Mischung weiterer Stände: Vom zdi-Zentrum, wo man Laufbürsten basteln konnte, die man anschließend mitnehmen durfte, bis zum Kriminalfall, dessen Lösung am Stand „Quanten-Materialien” mit einem Eis belohnt wurde. Der Roboterhund von Boston Dynamics vom Mechatronik-Stand, der immer irgendwo „rumschnüffelte” oder etwas zum Apportieren suchte, war wohl die beliebteste Attraktion für ein Selfie. Insgesamt war es eine schöne Gelegenheit, im Zentrum von Duisburg zu präsentieren, was an der Universität Duisburg-Essen passiert. Diese Gelegenheit wurde insbesondere von Familien mit Kindern genutzt.
10.07.2025Interview mit Tobias Roos – vom Auszubildenden zum Techniker an der UDE
Tobias Roos ist seit 2005 an der Universität Duisburg-Essen (UDE) tätig. Der Weg des gelernten Industriemechanikers begann mit einer Ausbildung an der UDE und führte ihn über verschiedene Stationen in seiner beruflichen Laufbahn. Heute arbeitet er als Techniker in der Arbeitsgruppe von Prof. Campen in der Physik, wo er zentrale Aufgaben in der Betreuung von Forschungsprojekten übernimmt.
07.07.2025Absolvent:innenfeier 2025
Am 04. Juli 2025 hat die Fakultät für Physik im Audimax LX die im Rahmen von Bachelorarbeiten, Masterarbeiten und Promotionen erbrachten Leistungen geehrt.
Dekan Prof. Dr. Michael Schreckenberg begrüßte die Absolvent:innen mit einer unterhaltsamen Ansprache und einem kurzen Vortrag über optische Täuschungen. Studiendekan Prof. Dr. Hermann Nienhaus stellt im Anschluss die Absolvent:innen vor und überreichte Ihnen, gemeinsam mit dem Dekan, eine Urkunde und Präsente. Es erfolgte die Ehrung der Arbeiten "mit Auszeichnung" und für das Engagement in Gremien der Fakultät.
Die Verleihung des Lehrpreises der Fachschaften an Prof. Dr. Jürgen König und Dr. Lothar Brendel und die Würdigung vier besonders origineller Fotos von Absolvent:innen bildeten einen schönen Abschluss des offiziellen Teils, bevor bei einem Empfang im Foyer bei Getränken und einem Snack angemessen gefeiert werden konnte.
Alle Teilnehmer:innen haben den Abend genossen und es war eine gelungene Veranstaltung. Wir wünschen allen diesjährigen Absolvent:innen erneut auf diesem Wege einen herzlichen Glückwunsch!
Ein Fotoalbum der Absolvent:innenfeier ist auf der Homepage der Veranstaltung zu finden
26.06.2025Von Klapppapierbrücken bis Wasserraketen – Auf die Plätze, freestyle-physics!
von Janina Balzer
Drei Monate hatten Schüler:innen der Klassen 5 bis 13 Zeit, anspruchsvolle technische Konstruktionsaufgaben zu lösen. Jetzt steht endlich das große Finale vor der Tür! Der Wettbewerb freestyle-physics zieht seit 2002 jährlich über 2.000 Schüler:innen an die Universität Duisburg-Essen. Die Aufgaben sind vielseitig. Traditionelle Elemente wie die Wasserrakete dürfen natürlich nicht fehlen, aber einiges ist auch neu.
Die Ideen werden am Campus Duisburg der Universität Duisburg-Essen (UDE) präsentiert und von Teams aus der Physik – vom Doktoranden bis zur Professorin – bewertet. Dabei zählen nicht nur gute Ergebnisse, sondern auch smarte und originelle Überlegungen. „Wir freuen uns ganz besonders, wenn schon mit ganz einfachen Mitteln, verblüffende Lösungen erzielt werden“, sagt Physiker Dr. Andreas Reichert aus dem Organisationsteam des Wettbewerbs.
Am 30. Juni geht’s los: Pro Disziplin werden die drei besten Lösungen ausgezeichnet, Sonderpreise gibt es für Kreativität. Ob Klapppapierbrücken, Raupen, Musikalische Kugelbahn, Gegenwindfahrzeuge oder Wasserraketen – bis Freitag, 4. Juli, steht einiges auf dem Plan:
Montag, 30. Juni: Klapppapierbrücken
Eine Brücke, die klapp-, ausfahr- oder zerlegbar ist, soll ein Gewicht von 400 g tragen und 80 cm überbrücken – und das mit möglichst wenig Eigengewicht und nur aus Papier, Bindfaden und Papierkleber.
Mittwoch, 2. Juli: Raupe und Musikalische Kugelbahn
Strecken, zusammenziehen, strecken, zusammenziehen – die Teams stellen sich der Challenge, ein zu Tier bauen, das sich selbstständig wie eine Raupe über 1,5 Meter fortbewegt. Parallel sind an diesem Tag kreative Klänge angesagt: Die Teams bringen Kugeln auf selbstgebauten Bahnen ins Rollen, und zwar möglichst geräuschvoll und melodisch.
Donnerstag, 3. Juli: Gegenwindfahrzeuge
Ein Fahrzeug bauen, das seine Antriebsenergie aus Gegenwind gewinnt – für die Köpfe der freestyle-physics bestimmt kein Problem! Aber: Welches ist auf 1,5 Metern das Schnellste?
Freitag, 4. Juli: Wasserrakete
Der jährliche Klassiker: Die Rakete wird mithilfe von einem Liter Wasser und Luftdruck gestartet. Die Wasserrakete, die am längsten in der Luft bleibt, gewinnt. Um die Flugzeit zu verlängern, können zum Beispiel Flügel oder Fallschirme verbaut werden.
Seit 23 Jahren nehmen jährlich Schüler:innen aus NRW und über dessen Grenzen hinaus an den freestyle-physics teil. Reichert staunt jedes Jahr erneut über das Ideenreichtum der Nachwuchs-Physiker:innen: „Es ist großartig zu sehen, wie kreativ die Kinder und Jugendlichen die Aufgaben lösen – ich bin jedes Mal wieder überrascht!“ Wer die freestyle-physics noch nicht kennt, bekommt im Kurzvideo einen ersten Eindruck. Neben dem Wettbewerb gibt‘s außerdem auch Laborführungen, Vorträge und Experimentalpraktika.
Weitere Informationen:
https://www.freestyle-physics.de/index.php
29.04.2025Mit 13 Jahren an die Uni Vom Klassenzimmer ins Physiklabor
von Janina Balzer
Mit 13 Jahren schon im Hörsaal? Für Jonathan Bork (Video hier) kein Problem. Neben der Schule nimmt er am Frühstudium der UDE teil, schreibt Klausuren in Physik und untersucht Siliziumwafer. Im Interview erzählt er, wie er alles unter einen Hut bringt.
Jonathan, du gehst in die 10. Klasse und besuchst die Uni – hast du nach mehr Herausforderung gesucht?
So kann man das sagen! Die Physik hat mich schon immer begeistert – Naturwissenschaften finde ich generell total spannend und davon wollte ich einfach mehr. Ich habe zufällig vom Frühstudium erfahren und dachte mir: Warum nicht? Also habe ich mich im Wintersemester 2024/2025 für eine Vorlesung angemeldet, ein Praktikum in einer Forschungsgruppe gemacht, und das hat mir so viel Spaß gemacht, dass ich dabeibleibe.
Was begeistert dich am Frühstudium?
Es ist eine toll, sein Wissen schon als Schüler in einem Fach zu vertiefen. Man bekommt Einblicke in das Uni-Leben, kann erste Erfahrungen sammeln und herausfinden, ob ein Studium in diesem Bereich wirklich das Richtige ist. Ich kann nur sagen: unbedingt ausprobieren!
Was machst du genau?
Ich besuche die Vorlesungen und Übungen zu Grundlagen der Physik, um mein Wissen zu erweitern. Parall dazu bin ich in der Arbeitsgruppe von Professor Martin Mittendorff. Dort geht es um Terahertz-Spektroskopie. Vereinfacht gesagt, geht es dabei um Strahlung, die zwischen dem Mikrowellen- und Infrarotbereich liegt. Wir nutzen sie, um mehr über Materialeigenschaften herauszufinden – zum Beispiel um zu sagen, wie gut ein Material Strahlung durchlässt oder reflektiert. Ich werde auch ein eigenes Projekt haben, in dem ich Siliziumwafer auf ihre reflexiven Fähigkeiten hin untersuche. Das sind ganz dünne Scheiben an hochreinem Silizium, die in der Halbleiterindustrie verwendet werden. Sie sind wichtig für die Herstellung von Mikrochips oder Solarzellen.
Wird die Schule da nicht langweilig?
Das Frühstudium und die Forschungsgruppe helfen mir tatsächlich auch in der Schule. Ich sehe alles noch einmal aus einem ganz anderen Blickwinkel. Besonders in Mathe. In der Physik steckt ja viel Mathematik, und mein Verständnis dafür ist durch das Studium viel besser geworden.
Wie bekommst du das alles unter einen Hut – Schule und Studium?
Meine Schule stellt mich für das Frühstudium frei. Und der Arbeitsaufwand ist machbar – mit der richtigen Organisation klappt das ganz gut. Mir gefällt auch das System an der Uni: Es gibt eine klare Trennung zwischen Vorlesungen und Übungen, das erleichtert das Lernen enorm. Die erste Vorlesung war natürlich trotzdem aufregend.
Bleibt denn noch Zeit für Freizeit?
Uni ist für mich wie Hausaufgaben. Danach habe ich noch Zeit für anderes: Ich spiele gerne Minecraft, treffe mich mit Freunden oder besuche die Pferde im Stall meiner Eltern. Außerdem engagiere ich mich auch noch für hybride Bildungskonzepte – das ist ein Herzensprojekt von mir.
Was ist hybride Bildung?
Es geht darum, Präsenzunterricht mit flexiblen Selbstlernphasen zu kombinieren. So können Schülerinnen und Schüler je nach Bedarf von zu Hause aus oder in der Schule lernen. Das hilft dann besonders hochbegabten oder neurodivergenten Kindern mit zum Beispiel ADHS oder Autismus, deren Gehirn anders als der neurotypische Standard funktioniert. Und dazu spreche ich mit Politikerinnen und Politikern oder präsentiere das Konzept auf Bildungsfestivals. In einigen Bundesländern wird mein Konzept auch schon verwendet, zum Beispiel an Berufsschulen in NRW oder an Projektschulen zu hybrider Bildung in Berlin. Schleswig-Holstein versucht gerade, das Konzept in den Regelschulen umzusetzen.
Ich habe schon mit Bildungsexperten auf der ganzen Welt gesprochen, ich bin zum Beispiel in Kontakt mit dem OECD Bildungsdirektor – hybride Bildung ist hier eine sehr günstige und effektive Möglichkeit. Deshalb ist es wichtig, dass noch mehr Bundesländer diese Ansätze übernehmen und langfristig das Bildungssystem moderner und inklusiver wird.
Was sind deine Ziele?
Erstmal das Abitur machen. Danach will ich auf jeden Fall Physik studieren. Langfristig könnte ich mir vorstellen, in der Forschung zu bleiben. Außerdem ist mir mein Engagement für hybride Bildung wichtig. Ich möchte das Konzept weiterentwickeln und Schulen sowie Politik dazu bringen, flexiblere Lernmodelle zu ermöglichen. Es wäre großartig, wenn mehr Schülerinnen und Schüler individuell und selbstbestimmt lernen könnten – so wie es auch beim Frühstudium möglich ist.
Die Fragen stellte Janina Balzer.
Im Bild:
Jonathan Bork im Physiklabor
29.04.2025Absolvent:innenfeier 2025 (Freitag, 04. Juli 2025)
Die Fakultät für Physik würdigt die im Rahmen von Bachelor-, Master- und Promotionsarbeiten erbrachten Leistungen.
Haben Sie einen der folgenden Abschlüsse zwischen Januar 2024 und Mai 2025 (einschließlich) erworben (Physik, Lehramt Physik, Energy Science, NanoEngineering mit Abschlussarbeit geschrieben in der Fakultät für Physik) und wurden bislang für Ihren Abschluss noch nicht gewürdigt?
- Bachelor
- Master
- Promotion
Dann sind Sie herzlich eingeladen.
Programm:
18:00 Uhr (Hörsaal LX 1205 Audimax, Lotharstraße 63a, 47057 Duisburg)
- Begrüßung durch den Dekan Prof. Dr. Michael Schreckenberg
- Vorstellung der Absolvent:innen
- Ehrung besonders herausragender Arbeiten durch den Dekan und durch den Studiendekan Prof. Dr. Hermann Nienhaus
- Verleihung des Lehrpreises der Fachschaften
20:00 Uhr (Foyer Hörsaalgebäude LX)
- Sektempfang mit Imbis
17.04.2025Von Phoenix Arizona nach Duisburg NRW - Dr. Brandt Gaches startet Emmy Noether-Gruppe zur Sternentstehung und Astrochemie
Die Mitglieder der Fakultät für Physik der Universität Duisburg-Essen freuen sich, Dr. Brandt Gaches zum Aufbau seiner Emmy Noether-Forschungsgruppe begrüßen zu können.
Für seine herausragenden Forschungsarbeiten auf dem Gebiet der kosmischen Strahlung und deren Wirkung in der Astrochemie wurde Dr. Brandt Gaches von der Deutschen Forschungsgemeinschaft mit einer „Emmy Noether-Gruppe“ ausgezeichnet. Damit ist neben der hohen Reputation auch eine Forschungsförderung von mehr als 1,5 Millionen Euro verbunden. Wir freuen uns, dass er ein Angebot unserer Fakultät für Physik angenommen hat, seine Gruppe bei uns aufzubauen. Die eigenständige Leitung einer Emmy Noether-Gruppe soll es ihm ermöglichen, sich in sechs Jahren für eine Universitätsprofessur zu qualifizieren.
Gaches und seine Gruppe werden vor allem die Wechselwirkung von kosmischer Strahlung mit dichtem, molekularem Gas während der Sternentstehung untersuchen. Gaches interessiert sich besonders für die chemischen Prozesse in der Umgebung von neu entstehenden, akkretierenden Sternen, sogenannten Protosternen. Im Universum bilden sich Sterne und Planeten in kaltem, dichtem Molekülgas. In dichtem Gas, das die ultraviolette Strahlung abschirmt, sind energiereiche geladene Teilchen, die so genannte kosmische Strahlung, die Hauptquelle der Ionisierung. Die Ionisierung wiederum treibt eine vielfältige Chemie in der Gasphase an. Ihre Wechselwirkung mit eisigen Staubkörnern stimuliert komplexe chemische Reaktionen. Die Ionisierungsrate der kosmischen Strahlung ist daher ein grundlegender Parameter in astrochemischen Modellen. Kosmische Strahlung wird durch die Beschleunigung von Teilchen, meist Protonen, auf sehr hohe Energien erzeugt. Diese verlieren jedoch auf ihrem Weg in Molekülwolken schnell an Energie. Deshalb wird nach neuen Quellen für niederenergetische kosmische Strahlung gesucht! Gaches hat die Fähigkeit neu entstehender Sterne, so genannter Protosterne, untersucht, während ihres Wachstums Teilchen zu beschleunigen, und eine neue Quelle dafür vorgeschlagen: die Beschleunigung in den allgegenwärtigen Turbulenzen innerhalb von Molekülwolken.
Gaches und seine Mitarbeiter haben auch einige der ersten dreidimensionalen chemischen Modelle von Sternentstehungswolken erstellt, die auch die Energieverlustprozesse der kosmischen Strahlung berücksichtigen. Schließlich ist Gaches Co-Investor zweier erfolgreicher James-Webb-Weltraumteleskop-Programme (PID 5064 und 8961), die darauf abzielen, zum ersten Mal die Strahlung von molekularem Wasserstoff nachzuweisen, die durch Wechselwirkungen mit kosmischer Strahlung entsteht.
Die faszinierenden Bilder des James-Webb-Weltraumteleskops sind eine äußerst umfangreiche Datenquelle für Gaches - sie faszinieren auch durch ihre unglaubliche Ästhetik.
Gaches verstärkt die beiden Professoren Rolf Kuiper und Gerhard Wurm und vergrößert das Potenzial für gemeinsame Forschungsinitiativen.
24.02.2025"Wissenschaft hautnah erlebt – Prof. Dr. Dietrich Wolf inspiriert Schüler*innen der Gesamtschule Horst"
Sen. Prof. Dr. Dietrich Wolf aus unserer Fakultät wurde mit großem Interesse empfangen, als er im Rahmen des Projektkurses Energy Science die Gesamtschule Horst besucht hat, um dort zum Thema "Energy Science" zu referieren und unseren gleichnamigen Studiengang vorzustellen. Folgender Artikel stammt von der Homepage der Schule:
"Schülerinnen und Schüler der Gesamtschule Horst erhielten im Fach Physik die Gelegenheit, mit einem renommierten Wissenschaftler der Universität Duisburg-Essen in einen direkten und praxisnahen Austausch zu treten. Prof. Dr. Dietrich Wolf, ein international anerkannter Physiker und Energieforscher, begeisterte die Schülerinnen und Schüler mit fundierten wissenschaftlichen Einblicken.
In enger Zusammenarbeit wurde ein Unterrichtskonzept entwickelt, das zentrale Themen der modernen Energiewissenschaften beleuchtet: Energieformen, mechanische Energieumwandlung, erneuerbare Energien, der Treibhauseffekt und der globale Energiebedarf. In fünf praxisorientierten Workshops wurden komplexe Konzepte durch interaktive und experimentelle Elemente vermittelt und greifbar gemacht.
Die Schülerinnen und Schüler erhielten exklusive Einblicke in aktuelle Forschung und universitäre Studieninhalte. Die Möglichkeit, auf höchstem akademischem Niveau zu diskutieren, erweiterte ihren fachlichen Horizont und stärkte nachhaltig ihre wissenschaftliche Denkweise sowie ihre Studienorientierung.
Es ist eine besondere Auszeichnung, dass ein Wissenschaftler von solcher Reputation seine Zeit investiert, um junge Talente zu fördern. Wir freuen uns darauf, diesen Austausch künftig weiter zu intensivieren."
18.02.2025Physikerin der Woche der Deutschen Physikalischen Gesellschaft - Ann-Sophie Meyer aus unserer Fakultät
Ann-Sophie ist Doktorandin in der Arbeitsgruppe von Marika Schleberger an der Universität Duisburg-Essen. Sie machte ihren Master of Education in Mathematik und Physik mit dem Ziel, Lehrerin zu werden. Nach ihrem Abschluss entschied sie sich jedoch für eine Forschungslaufbahn und ihre Promotion in Physik. Im Rahmen des SFB 1242 konzentriert sich ihre Forschung auf ultraschnelle Nichtgleichgewichtsdynamik in kondensierter Materie, insbesondere durch zeitaufgelöste ioneninduzierte Photoelektronenemissionsspektroskopie.
Simulationen sagen voraus, dass die Wechselwirkungs- und Relaxationsprozesse innerhalb der elektronischen und phononischen Systeme nach einem Ioneneinschlag auf Zeitskalen von Sub-Pikosekunden bis Nanosekunden ablaufen. Die experimentelle Verifizierung dieser Dynamik stellt jedoch eine echte Herausforderung dar, da die zeitliche Präzision des Ionenstoßes und die Erzeugung eines geeigneten (Sub-)Pikosekunden-Ionenpulses erforderlich sind. Im Rahmen des Projekts C05 des SFB 1242 wurde eine solche Quelle entwickelt, die die Erzeugung von Pikosekunden-Ionenimpulsen durch Femtosekunden-Photoionisation von Edelgasatomen ermöglicht.
Darauf aufbauend führt Ann-Sophie das weltweit erste Pump-Probe-Experiment mit Ionen als Pumpquelle durch. Ihre Arbeit untersucht die ioneninduzierte Nicht-Gleichgewichtsdynamik in Festkörpern und bietet beispiellose experimentelle Einblicke in diese Prozesse. Diese Forschung ist ein bahnbrechender Schritt zum Verständnis der grundlegenden ultraschnellen Dynamik, die durch Ionenstöße ausgelöst wird.
07.02.2025Rätsel gelöst – Symmetrie exotischer Kristall
Kristalle sind hochsymmetrisch, doch Quasikristallen fehlen wichtige Symmetrieeigenschaften. Diese Festkörper geben der Physik Rätsel auf. Eine Forschungsteam des Technion in Haifa, der UDE und der Universität Stuttgart hat nun eines davon gelöst. Es fand heraus, dass sich die Symmetrie in einer höheren Raumdimension verbirgt.
Bei der Untersuchung kollektiver Elektronenschwingungen (Plasmonen) auf Goldoberflächen entdeckten die Wissenschafter ein quasikristallines Muster. Angeregt durch frühere Plasmonen-Experimente suchten sie nach der fehlenden Symmetrie – und fanden sie im vierdimensionalen Raum. Hierzu waren zeitaufgelöste Mikroskopieexperimente auf einer Millionstel-Milliardstel Sekundenskala notwendig – eine Spezialität des Teams um Prof. Frank Meyer zu Heringdorf aus der Physik der UDE. Die Ergebnisse hat die internationale Forschungsgruppe jetzt im renommierten Magazin Science veröffentlicht.
Im Bild: Niederenergetisches Elektronenmikroskop der AG von Prof. Frank Meyer zu Heringdorf.
07.02.2025Veröffentlichung in Advanced Photonics – Spinmoment von Meronen ermittelt
von Birte Vierjahn
Einem Team unter der Leitung von Physiker:innen der Universität Duisburg-Essen ist es erstmals gelungen, die Spintextur zuvor erzeugter Meronen präzise zu ermitteln und daraus auf die topologischen Eigenschaften dieser Strukturen zu schließen. Ihre Erkenntnisse, veröffentlicht in Advanced Photonics, könnten dazu beitragen, Informationen künftig sicherer zu übertragen und zu speichern.
Elektronen, die sich kollektiv in einem Edelmetall bewegen, werden als Plasmonen bezeichnet. Sie werden etwa in der Katalyse oder in der Sensorik genutzt. Um die wellenartige Ausbreitung von Plasmonen an Edelmetalloberflächen zeitaufgelöst zu untersuchen, werden Laserpulse von wenigen Femtosekunden Dauer eingesetzt. Eine Femtosekunde entspricht dem Millionstel Milliardstel einer Sekunde. Mit einer noch einmal 10-fach besseren Zeitauflösung lässt sich die Bewegung von Plasmonenwellen in einem Photoelektronenmikroskop mit nahezu Lichtgeschwindigkeit in Raum und Zeit abbilden. Seit vielen Jahren entwickelt die Arbeitsgruppe um Prof. Dr. Frank-J. Meyer zu Heringdorf aus der Physik der Universität Duisburg-Essen (UDE) diese Art der zeitaufgelösten Mikroskopie. Ihre Arbeit hat weltweit Beachtung gefunden.
Nun ist es dem UDE-Team mit Kolleg:innen der Universitäten Stuttgart und Melbourne (Australien) Einmaliges gelungen: Sie haben mit bislang unerreichter zeitlicher und räumlicher Präzision die elektrische Feldstruktur von Plasmonenwellen so genau gemessen, dass daraus die topologischen Eigenschaften abgeleitet werden können. „Die Topologie ist eine mathematische Theorie, in der eigentlich unterschiedliche Objekte anhand übergeordneter geometrischer Eigenschaften klassifiziert werden können“, so Meyer zu Heringdorf. „Das bekannteste Beispiel ist wohl die topologische Gleichheit einer Tasse mit Henkel und eines Donuts: Beide sind unterschiedliche Objekte, aber beide haben genau ein Loch.“
Die Wissenschaftler:innen haben nun die lokale Spintextur eines sogenannten Meronenpaares untersucht. Meronen sind topologisch stabile Strukturen, bei denen sich Spinvektoren in bestimmter Art und Weise anordnen. „Überträgt man die Spinvektoren auf eine Kugel (so, wie Käsespießchen auf eine Melone), und wird nur eine Kugelhälfte von Vektoren bedeckt, so entspricht die Topologie der eines Merons“, erklärt der Physiker. Ein Meronenpaar besteht aus zwei identischen Meronen. „Für unsere Experimente haben wir ultrakurze Laserpulse genutzt, um die elektrischen Felder zu messen. Die magnetischen Felder konnten wir anschließend aus den gemessenen Daten ableiten und auf dieser Grundlage das Spinmoment berechnen.“
Das Forscherteam konnte so nachweisen, dass die Topologie des Plasmons konstant ist, obwohl das elektrische wie auch das magnetische Feld mit einer Periode von 2.66 Femtosekunden schwingen und rotieren. Diese Stabilität könnte künftig helfen, Informationen sicher zu speichern oder zu übertragen, denn topologisches Licht in Glasfasern wären resistenter gegen Verluste und Störungen.
Im Bild:
Spintextur eines Meronenpaares. Gezeigt sind die gemessenen Spinvektoren auf einer Goldoberfläche. Würden die Pfeile auf eine Kugel gesteckt, so würden sie zweimal die gleiche (nördliche) Halbkugel bedecken, während die südliche Halbkugel unbedeckt bliebe.
Originalpublikationen:
Advanced Photonics: https://doi.org/10.1117/1.AP.6.6.066007
Weitere Informationen:
Prof. Dr. Frank-J. Meyer zu Heringdorf, Experimentalphysik, Tel. 0203/37 9-1465, meyerzh@uni-due.de
10.02.2025Neue stellvertretende wissenschaftliche Direktorin bei CENIDE – Prof. Dr. Marika Schleberger
Der Vorstand des Center for Nanointegration Duisburg-Essen (CENIDE) hat Prof. Dr. Sebastian Schlücker aus der Fakultät für Chemie als neuen wissenschaftlichen Direktor und Prof. Dr. Marika Schleberger aus unserer Fakultät für Physik als stellvertretende wissenschaftliche Direktorin gewählt. Prof. Dr. Heiko Wende, ebenfalls aus der Physik, scheidet nach sechs Jahren aus dem Amt des wissenschaftlichen Direktors aus.
CENIDE ist ein interdisziplinäres Netzwerk der Universität Duisburg-Essen aus 79 Professoren/innen und Arbeitsgruppenleiter/innen – davon alleine 24 aus der Fakultät für Physik – das die „fächerübergreifende Zusammenarbeit fördert und hilft, die Lücke zwischen akademischer Grundlagenforschung und industrieller Umsetzung zu überbrücken“.
22.01.2025Veröffentlichung zur Planetenentstehung – Wachstum durch Kollision
Planeten entstehen, indem Staub und Gestein in einer Scheibe um einen jungen Stern kollidieren und sich zu immer größeren Körpern verbinden. Diese so genannte Akkretion ist bislang nicht vollständig verstanden. Astrophysiker der UDE konnten durch Experimente in einer Forschungsrakete wesentliche Beobachtungen zu Kollisionsgeschwindigkeit und elektrischer Ladung der Partikel machen. Ihre Ergebnisse wurden soeben in Nature Astronomy* veröffentlicht.
Bis aus einem mikrometerfeinen Staubkorn ein Planet mit einem Ausmaß von 10.000 Kilometern wird, vergehen Millionen von Jahren. Alles beginnt in einer scheibenförmigen Wolke aus Gas (99 Prozent) und Staub (1 Prozent), der protoplanetaren Scheibe: Hier stoßen die Staubpartikel zusammen und bilden Agglomerate. Wolken dieser Agglomerate kollabieren schließlich zu größeren Körpern, die Planetesimale genannt werden und bereits einen Durchmesser von ein bis hundert Kilometer haben können. Durch Gravitation ziehen die Planetesimale weitere Materie an, wachsen zu Protoplaneten und später zu vollwertigen Planeten heran.
Bei den Vorgängen in der Scheibe setzen die Partikel eine Kollisionsbarriere außer Kraft. „Eigentlich ist es nämlich so, dass Staubkörner ab etwa einem Millimeter Größe gar nicht wachsen können, weil sie voneinander abprallen oder sie beim Zusammenstoß zerbrechen“; erklären die Astrophysiker Prof. Dr. Gerhard Wurm und PD Dr. Jens Teiser. „Dadurch aber, dass sie immer wieder kollidieren, laden sie sich unterschiedlich auf und ziehen sich dann gegenseitig an.“
Die Haftung durch elektrostatische Aufladung hatte ihr Team schon in vorherigen Fallturmexperimenten beobachtet. Weil dabei nur knappe neun Sekunden Messzeit in Schwerelosigkeit möglich sind, konnten sie die finale Größe und die Stabilität der wachsenden Körper nicht untersuchen. Ganz anders in den Experimenten der aktuellen Studie: Sie fanden auf einer Forschungsrakete der Europäischen Weltraumorganisation ESA statt. „Während die Rakete auf 270 Kilometer Höhe aufstieg, bot sie uns sechs Minuten Schwerelosigkeit, unsere Experimente vom Boden aus zu steuern und zu verfolgen“, so Teiser.
Das UDE-Team konnte dadurch das Wachstum von kompakten Agglomeraten von etwa drei Zentimetern Größe direkt beobachten und genau messen, mit welcher Geschwindigkeit einzelne Partikel höchstens aufprallen dürfen, um nichts zu zerstören. „Die Agglomerate sind so stabil, dass sie den Beschuss von einzelnen Partikeln mit bis zu 0,5 Meter pro Sekunde aushalten. Alles darüber hinaus erodiert“, betont Astrophysiker Wurm. „Zusätzlich haben wir numerische Simulationen durchgeführt, die zeigen, dass es durch die Kollisionen tatsächlich zu einer starken elektrostatischen Aufladung und Anziehung kommt.“
„Derart konkrete Geschwindigkeiten für Erosion zu finden, hat uns überrascht“, ergänzt Teiser. „vor allem da sie nahe an jenen Werten liegen, die in früheren Simulationen für die Fragmentation verwendet wurden, also für das Zerbrechen von Partikeln oder Objekten.“ Das heißt, dass die physikalischen Bedingungen ähnlich sind, unter denen Material in der scheibenförmigen Wolke um einen jungen Stern abgetragen oder zerbrochen wird.
Die Ergebnisse des UDE-Teams fließen in physikalische Modelle zu protoplanetaren Scheiben und zum Partikelwachstum ein und helfen somit, die Details der Planetenbildung zu verstehen.
Die Forschungen wurden vom Deutschen Zentrum für Luft- und Raumfahrt (DLR) sowie vom Bundesministerium für Wirtschaft und Klima gefördert.
* Publikation: The growth of super-large pre-planetary pebbles to an impact erosion limit.
https://www.nature.com/articles/s41550-024-02470-x
Im Bild:
Geladene Partikel haben sich zu einem Agglomerat verbunden.
Weitere Information:
Prof. Dr. Gerhard Wurm, Astrophysik, Tel. 0203/37 9-1641, gerhard.wurm@uni-due.de
PD Dr. Jens Teiser, Astrophysik, Tel. 0203/37 9-2959, jens.teiser@uni-due.de
21.01.2025Luftlinie versus Straßennetz - Universeller Zusammenhang gefunden
Die direkte Verbindung zwischen zwei Orten per Luftlinie ist in der Regel kürzer als der Weg, den man per Auto zurücklegen muss. Zwei Physik-Arbeitsgruppen der Universität Duisburg-Essen haben nun herausgefunden: Die Entfernung zwischen zwei Orten in einem Autobahn-Netzwerk ist typischerweise 1,3-mal länger als deren Verbindung per Luftlinie. Ihre tatsächlich neue Erkenntnis basiert auf einer umfangreichen Analyse von Daten aus Europa, Asien und Nordamerika und wurde veröffentlicht im Fachmagazin npj Complexity.
Durchgeführt wurde die Studie von den Arbeitsgruppen Statistische Physik komplexer Systeme um Prof. Thomas Guhr sowie Physik von Transport und Verkehr unter der Leitung von Prof. Michael Schreckenberg. Sie ermittelten die Entfernung zwischen etwa 2.000 Orten innerhalb von Frankreich, Deutschland, Spanien, China und den USA. Dazu verwendeten sie frei nutzbare Geodaten und verglichen die Streckenlänge über das Autobahnnetz mit der jeweiligen geodätischen Entfernung – der direkten Verbindung zwischen zwei Orten, wie ein Vogel sie fliegen könnte. Sie fanden heraus, dass das Verhältnis der beiden Strecken recht universell ist: Die Strecke per Auto ist in der Regel 1,3 (± 0,1) mal länger als die Luftlinie.
„Dieses stabile Verhältnis über Länder und Kontinente hinweg ist das Ergebnis zweier gesellschaftlicher Bedürfnisse, die miteinander konkurrieren“, erklären die Leiter der Studie. „Zum einen möchten wir schnell und effizient an unser Ziel gelangen, zum anderen möchten wir Kosten und Umweltauswirkungen so gering wie möglich halten.“
Aus ihren Erkenntnissen wurde ein neues Modell für die Planung von Autobahn-Netzwerken abgeleitet, das sie als "teilweise zufälliges Autobahn-Netzwerk" bezeichnen. Es basiert auf der Idee, bestehende Verbindungen effizient zu nutzen, indem benachbarte Regionen schrittweise verbunden werden. Der zufällige Teil des Modells besteht darin, gewisse Verbindungen zwischen Städten und Orten im Autobahn-Netzwerk nur mit einer gewissen Wahrscheinlichkeit herzustellen. Definierte Regeln stellen dabei logische Verbindungen und eine gute Vernetzung sicher.
Das Modell könnte künftig die Effizienz von Verkehrswegen verbessern und gleichzeitig deren Umweltauswirkungen verringern.
Originalveröffentlichung: https://doi.org/10.1038/s44260-024-00023-x
Weitere Informationen:
Prof. Dr. Thomas Guhr, Statistische Physik komplexer Systeme, Tel. 0203/379-4730, thomas.guhr@uni-due.de
Prof. Dr. Michael Schreckenberg, Physik von Transport und Verkehr, Tel. 0203/379-3552, michael.schreckenberg@uni-due.de
Redaktion: Birte Vierjahn, Tel. 0203/37 9-2427, birte.vierjahn@uni-due.de
08.01.2025buddy@school digital 2025 - Infos für Studieninteressierte zu einem Energy Science- oder Physik Studium
In Kürze steht für alle, die in diesem Jahr die Schule abschließen, eine wichtige Entscheidung an: die Entscheidung für oder gegen ein Studium und die Wahl des Studienganges.
Die Fakultät für Physik der Universität Duisburg-Essen steht hierbei gerne unterstützend und mit Informationen und Hilfestellungen zur Seite. Wir präsentieren per Videokonferenz unsere Studiengänge Energy Science, Physik und Physik Lehramt an folgenden Terminen:
- Samstag, 01.02.2025, 13-14 Uhr
- Dienstag, 18.03.2025, 17-18 Uhr
- Montag, 24.03.2025, 17-18 Uhr
Anschließend kannst Du in einer lockeren Fragerunde Deine Fragen hierzu stellen. Ansprechpartner:innen sind dabei mindestens zwei Studierende aus unterschiedlichen Studiengängen und eine hauptamtliche Lehrkraft. Die Studierenden sind Teil unseres Buddy Systems. Innerhalb des Buddy Systems bieten wir eine Rundumberatung für zukünftige Studierende vor Beginn des Studiums und während der ersten beiden Semester. Weitere Informationen zum Buddy System können der Homepage des Buddy Systems und dem Flyer des Buddy Systems entnommen werden.
Wenn Du dieses Angebot (buddy@school digital 2025) nutzen möchtest, bitten wir Dich um eine einfache und kurze Anmeldung (spätestens eine Woche vor dem Wunschtermin) via Online-Formular unter https://udue.de/bas25 . Das Angebot steht natürlich auch denjenigen zur Verfügung, die erst in den kommenden Jahren die Schule abschließen werden, sich aber schon heute informieren möchten.
Wir freuen uns auf Dich!